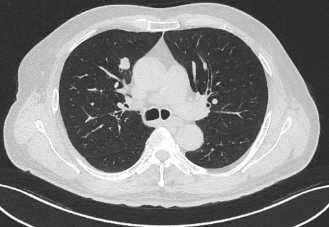
image.png

近日,昭通市中医医院呼吸与危重症医学科二科成功为一名合并多种基础疾病的61岁肺癌患者实施了昭通首例经口支气管镜超声(EBUS)引导下肺癌冷冻消融术。该患者因“反复咳嗽、咳痰1年,确诊右肺鳞癌2月余”入院。胸部增强CT显示其右肺上叶存在两个高危结节(Lung-RADs 4X类),同时合并慢性支气管炎伴肺气肿、肺炎、冠心病(支架术后)、肺大疱、肺不张等疾患。

术前患者CT
鉴于患者病情复杂、基础病多,传统手术风险极高。呼吸二科联合神经内科、影像科、麻醉科、ICU等多学科(MDT)深入评估后,最终确定行微创的“经口支气管镜超声引导下肺癌冷冻消融术”。该方案旨在精准定位并直接冻融灭活肿瘤组织,最大限度减少创伤。




术中
手术在全麻气管插管下顺利完成。术中,在EBUS精确定位下,团队将冷冻探头精准置入右肺上叶尖段及前段支气管壁的新生病灶。分区域对两处肿瘤分别进行了4个循环的精确冷冻消融,使肿瘤组织充分凝固坏死。术程顺利,未出现明显出血或气胸,患者生命体征平稳。


术后患者CT
术后患者咳嗽、咳痰症状显著缓解,目前正接受抗感染、抗炎、化痰及营养支持等个性化康复治疗。此例手术的成功标志着我院呼吸介入诊疗水平取得重要突破,为因身体条件无法耐受常规手术的肺癌患者提供了新的、有效的微创治疗选择,充分体现了医院在复杂肺部疾病综合诊疗领域的实力。
友情链接:
24小时行政总值班:0870-2230658
24小时急救电话:0870-2120120
联系电话:0870-2233331 地址:云南省昭通市昭阳区团结路26号
版权所有 Copyright © 昭通市中医医院 滇ICP备20001378号-4 本站部分素材源于网络,如有侵权,请联系作者删除!
技术支持:川海科技